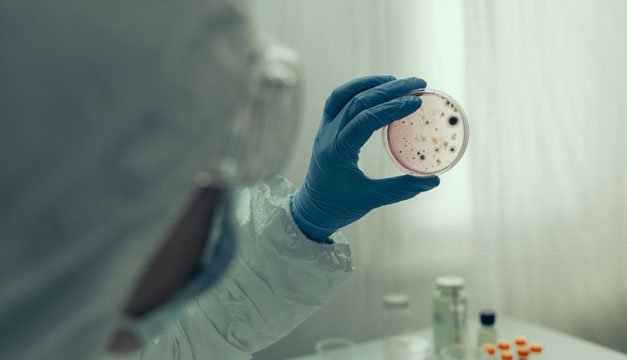
República Dominicana vacuna "casa a casa" para contener brote de cólera

Los síntomas de la diabetes es una de las enfermedades que más a la población mundial. Según la Organización Mundial de la Salud (OMS), alrededor de 350 millones de personas en todo el mundo sufren de esta enfermedad metabólica.
El término "diabetes mellitus" abarca diversas enfermedades que tienen en común una alteración del metabolismo y niveles elevados de azúcar en la sangre y no causa síntomas.
En nuestro país se estima que más de dos millones de personas padecen de esta enfermedad. A pesar de ello muchos desconocen su padecimiento, ya que la diabetes generalmente se desarrolla de forma silenciosa y no causa síntomas agudos.
¿Qué es la diabetes tipo 2?
En la diabetes tipo 2 las células del cuerpo se vuelven cada vez más insensibles a la hormona insulina, que se encarga de promover la absorción de glucosa desde el torrente sanguíneo hacia las células para generar energía.
El resultado de la creciente insensibilidad de las células es que aumenta el nivel de azúcar en la sangre. La población más afectada son las personas mayores, pero cada vez más también los jóvenes.
Algunos factores de riesgo son principalmente una predisposición genética, sobrepeso y falta de ejercicio físico.

¿Qué es la diabetes tipo 1?
La segunda forma más común es la diabetes tipo 1 . En este caso es una enfermedad autoinmune, ya que el mismo sistema destruye las células de los islotes pancreáticos que producen la hormona insulina. Por lo tanto, hay una deficiencia de insulina.
Con el fin de tratar los niveles elevados de azúcar en la sangre, los pacientes generalmente tienen deben inyectarse insulina toda su vida.
Posibles síntomas que indican diabetes
Micción frecuente
Los pacientes pueden tener un aumento de la urgencia urinaria (poliuria). A menudo, este es el primer signo de diabetes.
Sed excesiva
El aumento de la micción puede conducir a la falta de agua. Afectado, entonces siente una mayor necesidad de beber.
Piel seca o con picazón
La piel seca puede ser un primer síntoma de diabetes. También surge cuando el cuerpo excreta más azúcar a través de la orina y pierde líquido.
Fatiga
La diabetes puede hacer que las personas se sientan soñolientas.
Pérdida de peso
En algunos casos, la diabetes causa pérdida de peso. Esto se debe, por una parte, a la pérdida de fluidos como resultado del aumento de la urgencia urinaria.
Otra posible causa, pero especialmente en la diabetes tipo 1 ocurre: si las células ya no pueden cubrir adecuadamente sus necesidades energéticas debido al deterioro del azúcar en la sangre, el cuerpo recurre a depósitos de grasa y los afectados pierden peso.
Las heridas sanan mal
En la diabetes, el sistema inmunitario a menudo se debilita. Esto y una circulación más pobre de la piel ayudan a que las heridas cicatricen más lentamente.
Mayor susceptibilidad a las infecciones
Los diabéticos son más susceptibles a diversas enfermedades infecciosas, como infecciones del tracto urinario, pie de atleta u otras infecciones de la piel. La enfermedad periodontal también es más común en la diabetes.
La respiración huele a acetona
Solo en la diabetes tipo 1, se puede sentir un olor a acetona en la respiración, que recuerda a la fruta demasiado madura. Si el azúcar insuficiente entra en las células, el cuerpo descompone las células grasas.
Esto produce, entre otros, acetona. Es un signo de deficiencia grave de insulina que puede conducir a cetoacidosis y en el peor de los casos, coma diabético.
Hoy que conoces los síntomas de la diabetes, puedes leer esta nota para cuidar a tus hijos LOS NIÑOS, LA DIABETES Y LA ESCUELA
El diagnóstico de diabetes como una oportunidad
En el caso de los pacientes con diabetes tipo 2 es importante que cambien su estilo de vida con más ejercicio y la alimentación saludable.
En cualquier caso, el diagnóstico es también una oportunidad. Porque con el procedimiento adecuado, muchos pacientes pueden mejorar su metabolismo, los síntomas a menudo alivian significativamente y por lo tanto atraen más la calidad de vida.